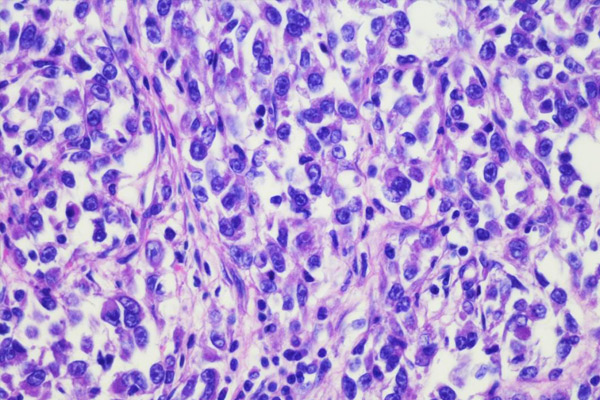
Sarcomas
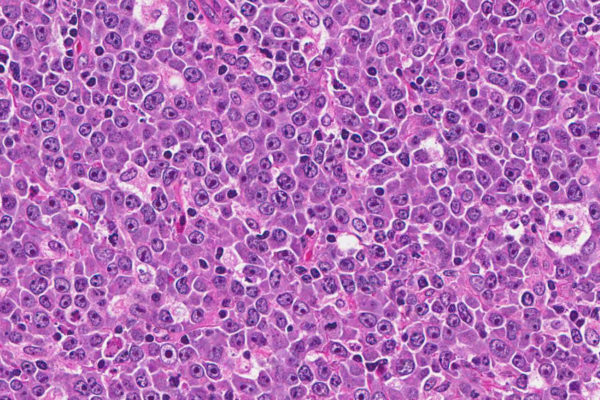
Lymphomas

Know Cancer
What is Cancer?
Cancer is the name given to a collection of related diseases. In all types of cancer, some of the body’s cells begin to divide without stopping and spread into surrounding tissues. Cancer can start almost anywhere in the human body, which is made up of trillions of cells. Normally, human cells grow and divide to form new cells as the body needs them. When cells grow old or become damaged, they die, and new cells take their place.
When cancer develops, however, this orderly process breaks down. As cells become more and more abnormal, old or damaged cells survive when they should die, and new cells form when they are not needed. These extra cells can divide without stopping and may form growths called tumors.
Read more
Cancer Symptoms
General signs and symptoms
You should know some of the general signs and symptoms of cancer. But remember, having any of these does not mean that you have cancer – many other things cause these signs and symptoms, too. If you have any of these symptoms and they last for a long time or get worse, please see a doctor to find out what’s going on.
Most people with cancer will lose weight at some point. When you lose weight for no known reason, it’s called an unexplained weight loss. An unexplained weight loss...
Read more
Fever is very common with cancer, but it more often happens after cancer has spread from where it started. Almost all people with cancer will have fever at some time, especially...
Read more
Fatigue is extreme tiredness that doesn’t get better with rest. It may be an important symptom as cancer grows. But it may happen early in some cancers, like leukemia...
Read more
Pain may be an early symptom with some cancers like bone cancers or testicular cancer. A headache that does not go away or get better with treatment may be a...
Read more
Along with skin cancers, some other cancers can cause skin changes that can be seen. These signs and symptoms include: Darker looking skin (hyperpigmentation)...
Read more
Skin cancers may bleed and look like sores that don’t heal. A long-lasting sore in the mouth could be an oral cancer. This should be dealt with right away, especially...
Read more